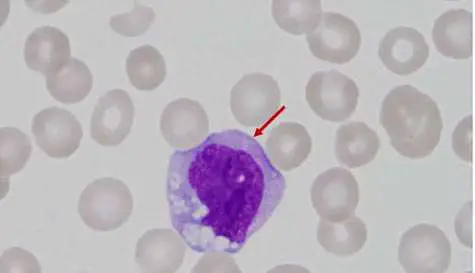
圖片描述

113年:(醫檢)血液(1)
圖中箭號所指的血球為何?
AMonocyte
BReactive lymphocyte
CPromyelocyte
DBlast
詳細解析
本題觀念:
鑑別周邊血液抹片中各種白血球之成熟度與細胞亞型,重點在於 monocyte 與 reactive lymphocyte、promyelocyte、blast 等細胞在核型、細胞質顏色、顆粒及真空空泡等形態學差異。
影像分析:
從圖中可見該細胞直徑明顯大於紅血球(約14–20µm)、細胞質豐富呈灰藍色,具散在大小不一的空泡(vacuoles),且可見細微粉紅或淡紫色顆粒呈「毛玻璃(ground-glass)」狀;細胞核輪廓不規則,呈腎形或馬蹄形,染色較淺、染質細緻柔軟,無明顯核仁(nucleoli)顯示。整體形態符合 monocyte 之典型特徵 (labce.com)。
選項分析
- 選項A Monocyte
特徵吻合:細胞體積大(14–20µm)、細胞質藍灰且呈 ground-glass、常見 cytoplasmic vacuoles、核染質細而柔軟呈腎/馬蹄形,無明顯核仁 (labce.com)。 - 選項B React
...(解析預覽)...

升級 VIP 解鎖圖文解析